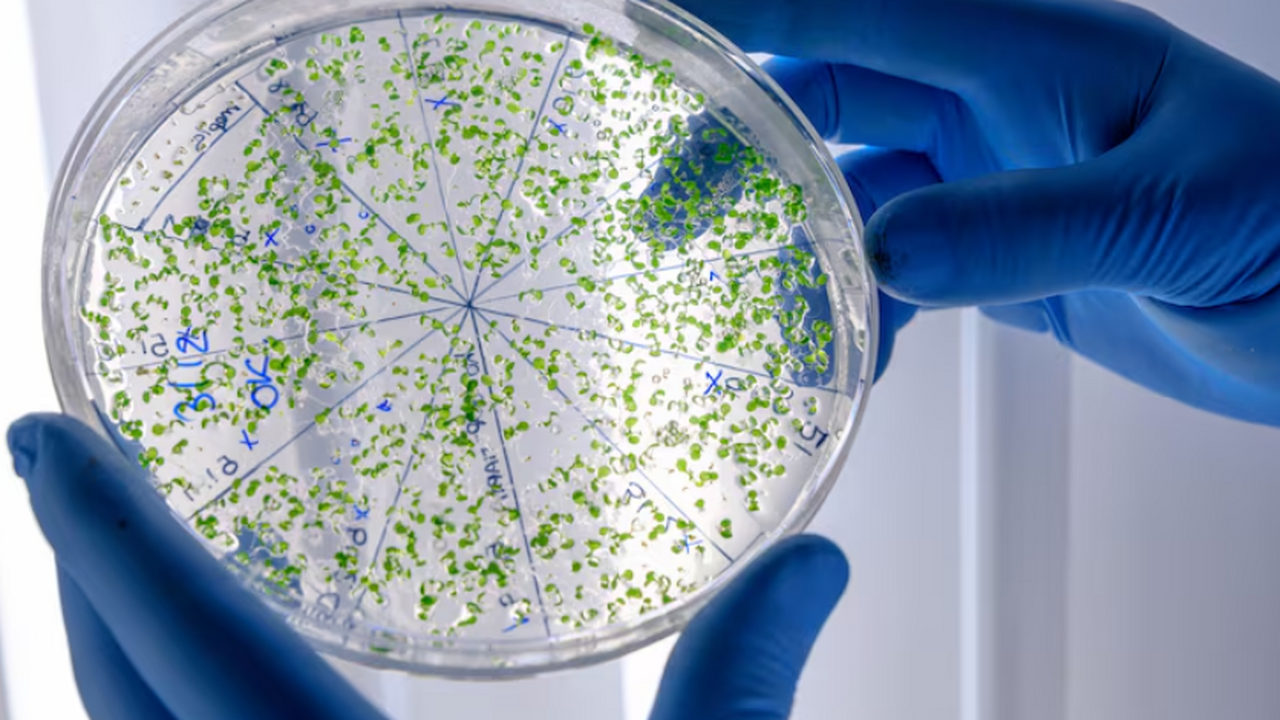

Расшифрована 3D‑структура древней бактерии с гигантским комплексом из 500 белков
freepik.com
Российские исследователи определили трехмерную структуру гигантского светособирающего комплекса древней цианобактерии Gloeobacter violaceus. Об этом сообщили в ФИЦ Биотехнологии РАН со ссылкой на публикацию в Science Advances. Речь идет о фикобилисомe — крупном комплексе, улавливающем свет и передающем его энергию внутри клетки. Конструкция включает более 500 белков. Строение такого комплекса оставалось неясным почти полвека с момента его описания.
Для установления полноатомной модели использовали криоэлектронную микроскопию. Авторы отмечают, что это первая детальная 3D‑реконструкция фикобилисомы нового типа и описание механизмов ее регуляции. Полученные данные расширяют понимание эволюции фотосинтетического аппарата у древних фотосинтезирующих организмов.
По оценке ученых, результаты могут ускорить разработку природоподобных фотоэлементов. В исследовании участвовали также специалисты МГУ, Института физиологии растений им. К. А. Тимирязева РАН и НИЦ Курчатовский институт. Работа выполнена при поддержке Российского научного фонда.
Обратите внимание: Стало известно, как сильно вырастут выплаты, зависящие от социальной пенсии в России
Сообщает ТАСС
Источник: samaraonline24.ru
Читайте в Дзен